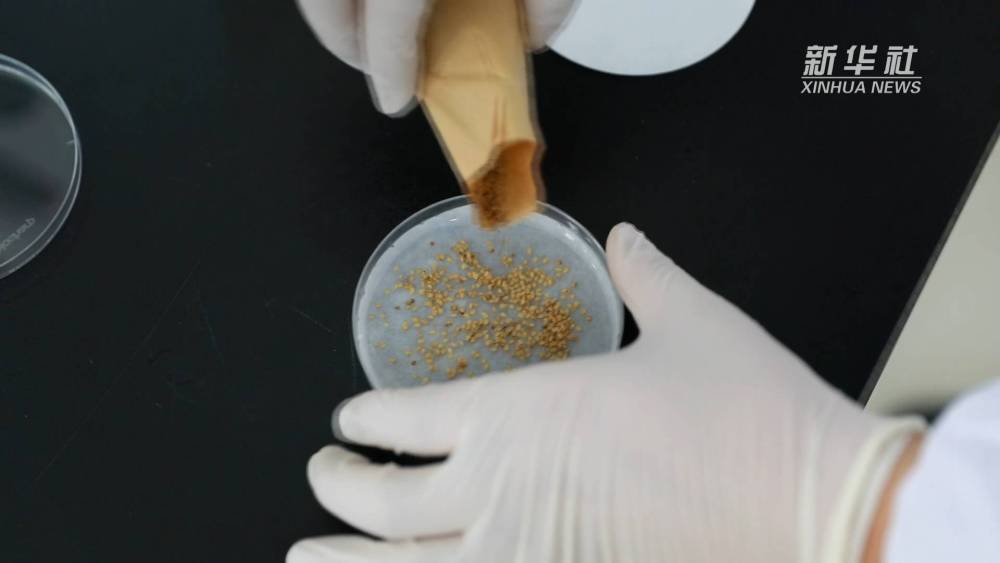

甘肃省定西市渭源县有“中国马铃薯良种之乡”的美誉。近年来,渭源围绕马铃薯产业健康发展,不断加快种业研发,持续做强农业“芯片”。

多年来,负责马铃薯良种研发、扩繁重任的渭源县把马铃薯产业作为战略性主导产业来培育,构建起了马铃薯“种薯扩繁、质量监管、科研服务、贮藏销售、品牌宣传、精深加工”六大产业发展体系,聚焦良种培育,全力推动马铃薯产业实现集群化全链条发展。

近年来,渭源县在甘肃省农业科学院等科研机构的大力支持下,通过自主研发试验、引进筛选、多品种繁育和市场化推广,不断促进马铃薯良种优化升级,育种能力持续保持国内领先水平。 记者:郭刚、马莎










